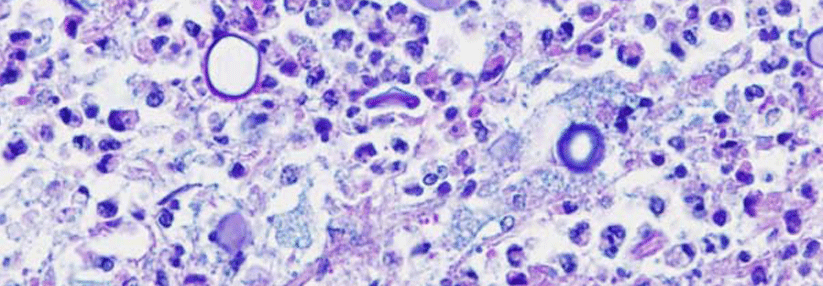

Appendektomie fünf Monate nach Malawi-Reise brachte Schistosomiasis ans Licht
 Nachträglich wurde der Wurmfortsatz biopsiert. Neben einer eosinophilen Entzündung fanden sich auch Schistosomeneier.
© Mit freundlicher Genehmigung von Dr. Christian Kraef, c.kraef@uke.de, Department of Tropical Medicine, Bernhard Nocht Institute for Tropical Medicine & I. Department of Medicine, University Medical Center Hamburg-Eppendorf, Hamburg
Nachträglich wurde der Wurmfortsatz biopsiert. Neben einer eosinophilen Entzündung fanden sich auch Schistosomeneier.
© Mit freundlicher Genehmigung von Dr. Christian Kraef, c.kraef@uke.de, Department of Tropical Medicine, Bernhard Nocht Institute for Tropical Medicine & I. Department of Medicine, University Medical Center Hamburg-Eppendorf, Hamburg
Die Laborwerte des jungen Mannes zeigen eine Leukozytose, Eosinophilie und leicht erhöhte Leberwerte. Zusammen mit den akuten Bauchschmerzen passt das für die Ärzte im regionalen Krankenhaus zu einer akuten Appendizitis und sie schreiten zur Tat.
Bei der intraoperativen Inspektion bemerken die Chirurgen ungewöhnliche weiße Areale auf der Leberoberfläche. Laut Biopsie handelt es sich um nekrotische Granulome mit Eosinophilen. Das postoperative CT zeigt noduläre pulmonale Infiltrate und eine Hepatomegalie ohne spezifische Läsionen. Der Patient wird daraufhin zur weiteren Diagnositk ins Universitätsklinikum Hamburg-Eppendorf (UKE) überwiesen.
Schon zu Beginn hatte er von einer gelb-bräunlichen Verfärbung seines Ejakulats berichtet. Die erneute Befragung ergibt jetzt, dass der 17-Jährige zwei Monate in Malawi war, wo er häufig im See gebadet hatte – zuletzt fünf Monate vor Symptombeginn.
Dr. Christian Kraef von der I. Medizinischen Klinik am UKE und seine Kollegen können im Blut und Ejakulat über PCR den Befall mit Schistosoma haematobium nachweisen. Zusätzlich finden sie vitale Eier des Pärchenegels in der Spermaprobe. Die nachträgliche Histologie des entfernten Appendix identifiziert ebenfalls Granulome mit Wurmeiern. Eine dreitägige Therapie mit Praziquantel (40 mg/kg KG oral) führt zur vollständigen Genesung.
Weltweit leiden 250 Mio. Menschen an Schistosomiasis. Aufgrund der langen Inkubationszeit und der unspezifischen Symptome wird die Erkrankung primär häufig übersehen, schreiben die Autoren. Durch globales Reisen und Migration können auch Menschen in nicht endemischen Gebieten betroffen sein. Daher empfehlen die Kollegen, vermehrt Themen wie Reisegewohnheiten bei der Anamnese anzusprechen.
Quelle: Kraef C et al. Lancet 2018; 391: 2546
Fotos: Mit freundlicher Genehmigung von Dr. Christian Kraef, c.kraef@uke.de, Department of Tropical Medicine, Bernhard Nocht Institute for Tropical Medicine & I. Department of Medicine, University Medical Center Hamburg-Eppendorf, Hamburg
 Neben einer eosinophilen Entzündung fanden sich auch Schistosomeneier.
© Mit freundlicher Genehmigung von Dr. Christian Kraef, c.kraef@uke.de, Department of Tropical Medicine, Bernhard Nocht Institute for Tropical Medicine & I. Department of Medicine, University Medical Center Hamburg-Eppendorf, Hamburg
Neben einer eosinophilen Entzündung fanden sich auch Schistosomeneier.
© Mit freundlicher Genehmigung von Dr. Christian Kraef, c.kraef@uke.de, Department of Tropical Medicine, Bernhard Nocht Institute for Tropical Medicine & I. Department of Medicine, University Medical Center Hamburg-Eppendorf, Hamburg